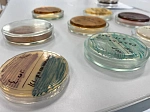
Ученые БГМУ Минздрава России разработали отечественную тест-систему для идентификации «бактерии стройности»

Ученые БГМУ Минздрава России разработали отечественную тест-систему для идентификации «бактерии стройности»
Ученые лаборатории микробиома человека Башкирского государственного медицинского университета в Межвузовском студенческом кампусе разработали инновационную отечественную тест-систему, которая позволяет быстро, точно и с минимальными финансовыми затратами определять количество бактерии Akkermansia muciniphila в организме человека. Эта микрокультура, неофициально именуемая «бактерией стройности», является ключевым маркером здоровья метаболизма человека.
Akkermansia muciniphila обитает в кишечнике здорового человека и составляет от 1 до 4% от всей микробиоты. Дефицит этой бактерии напрямую связан с развитием ожирения, сахарного диабета 2-го типа и воспалительных заболеваний кишечника, а избыток может привести к развитию онкологических заболеваний.
До недавнего времени точное количественное определение данного вида бактерии в клинических образцах для ученых представляло сложную задачу. Раньше Akkermansia, как строгий анаэроб, была крайне сложна для идентификации. Единственным достоверным способом считалось полногеномное секвенирование, что являлось длительным и дорогостоящим процессом. Для рутинной диагностики это нецелесообразно.
Команда ученых БГМУ Минздрава России вышла за рамки существующих аналогов. Если ранее исследования позволяли подобрать праймеры только к роду бактерий, то башкирские ученые разработали нуклеотидные праймеры и зонды для вида Akkermansia muciniphila.
Новая тест-система на основе полимеразной цепной реакции работает по принципу, схожему с тестами на коронавирус, но нацелена на выявление конкретной бактерии. Это позволяет проводить как качественный, так и количественный анализ.
Внедрение разработки открывает эру доступной персонализированной диагностики. Тест-система БГМУ Минздрава России значительно дешевле секвенирования, что делает мониторинг состояния микробиоты доступным для клиник и научных центров.
Разработка имеет двойное назначение с одной стороны – это объективный мониторинг эффективности терапии для пациентов с метаболическими нарушениями, с другой - фармацевтические компании смогут использовать тест для проверки наличия и количества штамма в пробиотических препаратах перед регистрацией и выпуском на рынок.
Успеху исследования способствовала поддержка в рамках программы стратегического академического лидерства «Приоритет-2030». Благодаря финансированию в лабораторию было закуплено современное анаэробное оборудование, позволяющее работать с чувствительными культурами.
«Мы не просто нашли бактерию, мы нашли применение этому знанию. Тест-система поможет врачам управлять микробиомом для профилактики целого спектра социально значимых заболеваний», ректор БГМУ Минздрава России, академик РАН, профессор Валентин Павлов.
Ученые Университета сделали шаг к импортозамещению в сфере медицинской диагностики и созданию новых подходов к лечению через управление микробиотой человека.
СМИ О НАС: https://www.gazeta.ru/science/news/2026/03/19/28083667.shtml?utm_auth=false